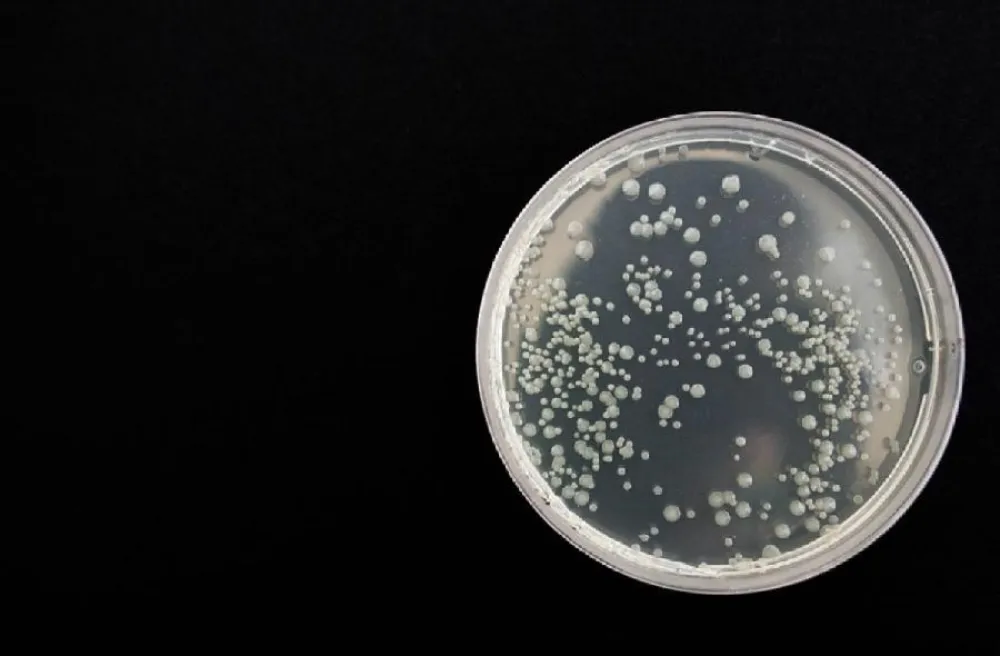
Foto ilustracija

Foto ilustracija
Preuzmite našu aplikaciju
PRATITE NAS NA
PRIDRUŽITE NAM SE NA VIBER
COMMUNITY
PRATITE NAS
I NA TELEGRAM KANALU
PRATITE NAS
I NA WHATSUP KANALU
Naučnici na dobrom putu da razviju prvu vakcinu protiv fatalnih gljivica
U nedavnoj studiji, eksperimentalna vakcina je dizajnirana da zaštiti od tri najčešća uzročnika gljivičnih infekcija – Aspergillus, Candida i Pneumocistis – koji su odgovorni za više od 80 procenata smrtonosnih gljivičnih infekcija
Za sada ne postoji odobrena vakcina za gljivične infekcije, ali se naučnici nadaju da će njihov rad uroditi plodom.
Ilustracija (Foto: pixabay)
Naučnici razvijaju vakcinu za koju se nadaju da bi mogla da bude prva imunizacija za borbu protiv invazivnih gljivičnih infekcija. Iako je do sada testirana samo na životinjama, istraživanje bi na kraju moglo da utaba put vakcini širokog spektra koja bi mogla da se uhvati u koštac sa rastućom prijetnjom gljivica otpornih na lijekove, piše IFL Science.
U nedavnoj studiji, eksperimentalna vakcina je dizajnirana da zaštiti od tri najčešća uzročnika gljivičnih infekcija – Aspergillus, Candida i Pneumocistis – koji su odgovorni za više od 80 procenata smrtonosnih gljivičnih infekcija.
Eksperimenti Univerziteta u Džordžiji su pokazali da glodari i primati, koji nijesu ljudi, a koji su primili vakcinu, imali znatno veće šanse za preživljavanje u poređenju sa nevakcinisanim životinjama.
Ovaj uspjeh je potkrijepljen dokazima koji su pokazali da je vakcina bila efikasna u razvoju zaštitnih antitijela protiv sva tri gljivična patogena.
„Kako cilja na tri različita patogena, vakcina ima potencijal da bude revolucionarna u pogledu invazivnih gljivičnih infekcija“, rekla je Karen Noris, vodeći istraživač i profesor na Fakultetu veterinarske medicine.
Ona je dodala da su u toku planovi za razvoj vakcine koja bi se koristila za ljude. U pitanju je prva faza u kojoj se ispituje njena bezbjednost.
Trenutno nema odobrenih vakcina za gljivične infekcije, a zabrinutost zbog prijetnje gljivičnih infekcija otpornih na ljekove raste.
Novi eksperimentalni tretmani su u toku, ali je jasno da svijet nije spreman za porast gljivičnih infekcija otpornih na ljekove.
Prva linija odbrane od ljudskih gljivičnih infekcija je obično liječenje azolima, koji su antifungalni ljekovi širokog spektra. Međutim, sve je veći broj slučajeva takozvanih supergljivica koje su razvile otpornost na ove ljekove zbog prekomjerne upotrebe antifungalnih agenasa.
Na primjer, 2021. godine, otkriveno je da se gljivične infekcije otporne na ljekove koje su bile potpuno otporne na sve glavne klase antifungalnih ljekova po prvi put šire među hospitalizovanim pacijentima u SAD.
Naučnici širom svijeta su takođe prijavili porast „lukavih“ gljivičnih infekcija među pacijentima sa kovidom-19 tokom pandemije.
Ko je u rizičnoj grupi?
Glavna grupa ljudi u riziku su oni sa oslabljenim imunološkim sistemom, posebno ako borave u bolničkom okruženju gdje infekcije mogu da se šire poput požara. Za ove ljude, vakcina koja štiti od invazivnih gljivičnih infekcija ima potencijal da bude spasonosna.
Međutim, kako je tretman još uvijek u ranoj fazi testiranja, proći će neko vrijeme prije nego što ova vakcina postane korisna za pacijente.
„Ovo je oblast koja je dugo bila nedovoljno razvijena na istraživačkom frontu“, dodala je Noris, koja je takođe istaknuta naučnica iz Saveza za istraživanje u oblasti imunologije i translacione biomedicine u Džordžiji.
Ona je dodala da je velika populacija ljudi koji su u opasnosti od invazivnih gljivičnih infekcija, i iako su uloženi značajni napori da se razviju vakcine, nijedna još nije odobrena.
„Vjerujemo da je ovo veoma jak kandidat za vakcinu“, rekla je naučnica.
Studija je objavljena u časopisu PNAS Nexus u novembru 2022.
Preuzmite našu aplikaciju
PRATITE NAS NA
PRIDRUŽITE NAM SE NA VIBER
COMMUNITY
PRATITE NAS
I NA TELEGRAM KANALU
PRATITE NAS
I NA WHATSUP KANALU









